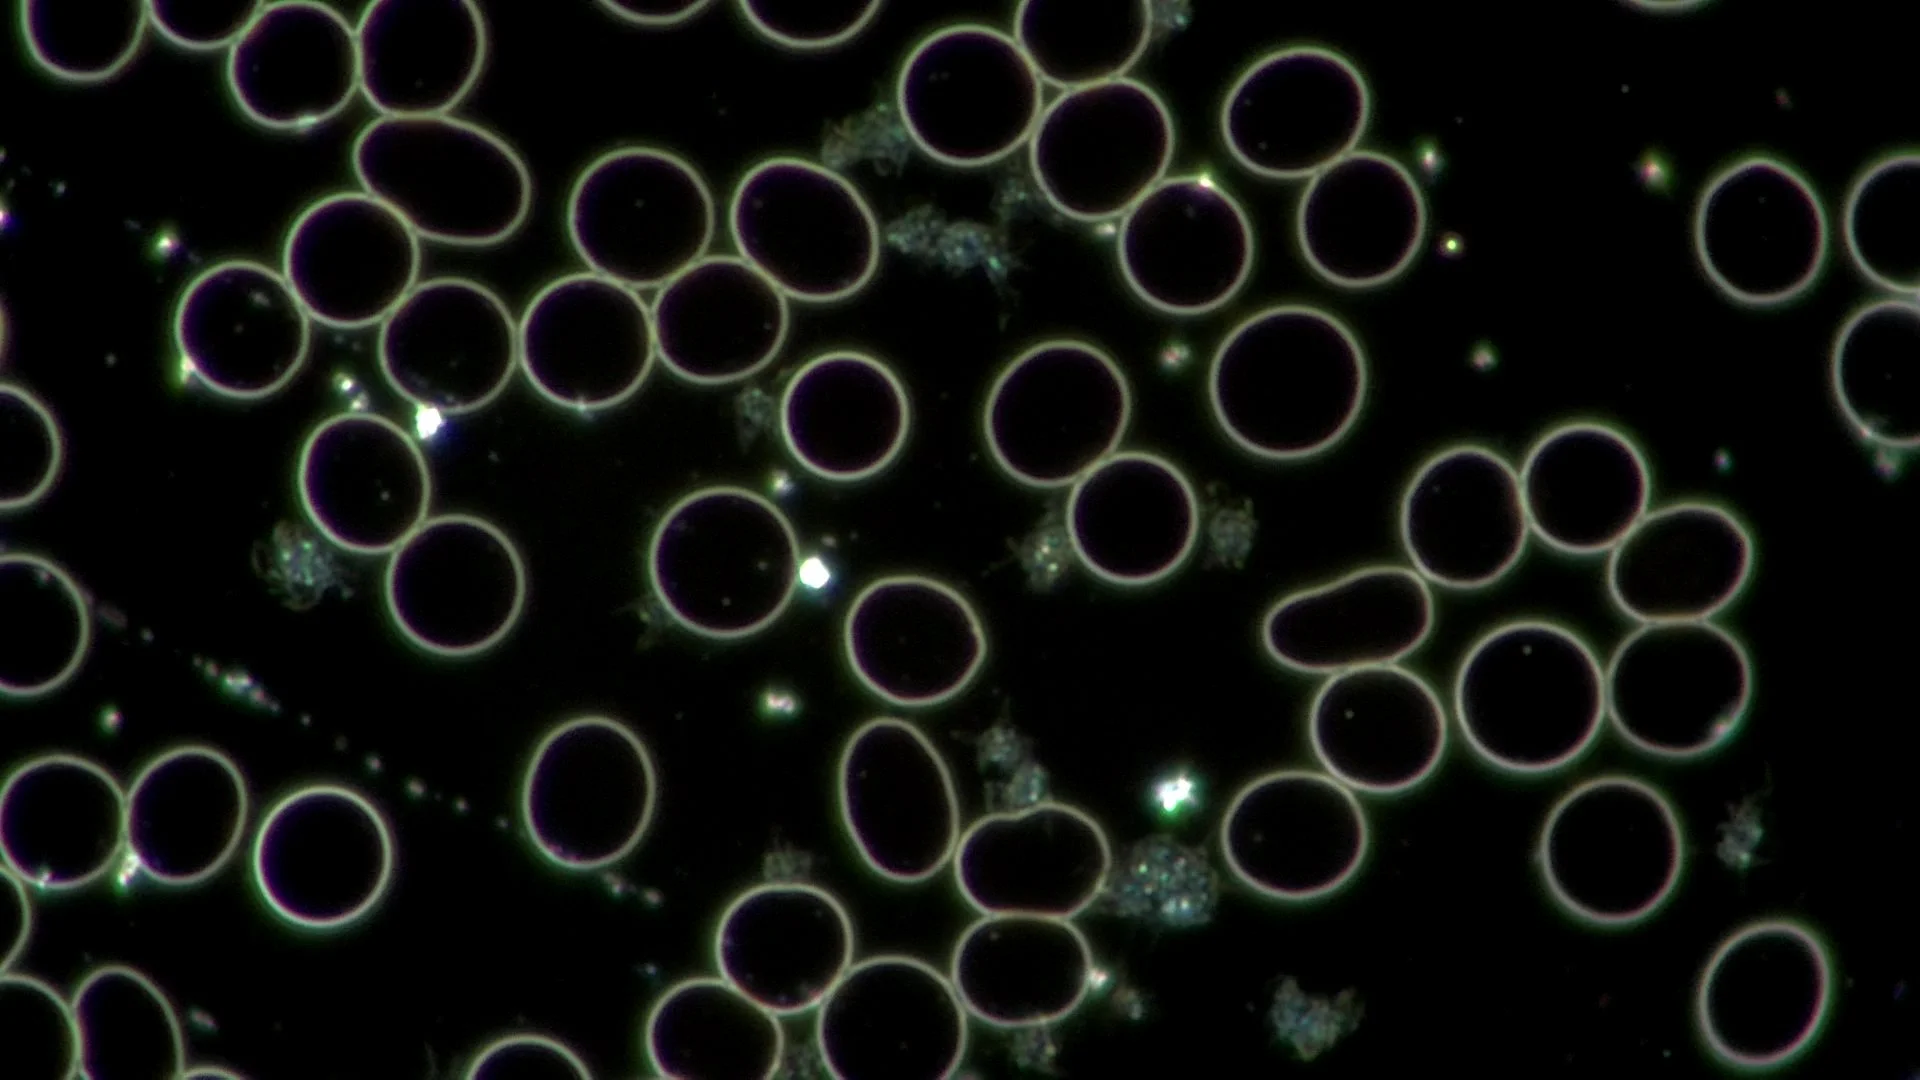

Free 7-Day Breathwork Challenge
See what your breath can do for you
Try the 7-day challenge:
Download the session below
Do it once a day for the next 7 days
Notice the difference in your mind, body and energy!
Release stress, shift your Nervous System, and reclaim your health with breathwork
Before Breathwork

Feeling stressed, frustrated and overwhelmed
The live blood cell image reflects the stress her emotional state is having on her physiology. These cells stack together as ‘coins.’ This indicates there is inflammation, dehydration and possibly an acidic cellular environment. Long-term this can lead to physical health imbalances and chronic diseases.
After Breathwork
Feeling grounded, calm and mind is at peace
After 15 minutes of breathwork, her blood health has significantly improved. Cells can move freely, and stress has been eliminated. Through her breath, she has not only calmed her mind and changed her emotional state, but she also shifted her biology and the health of her body.
What is Breathwork?
Breathwork is a general term that refers to using intentional breathing to support healing. For centuries, cultures around the world have practiced breathwork, finding their unique way of using conscious breath to change the mind and body.
In Embodiment and Somatic Breathwork, we utilize a variety of patterns and holds to release density (trauma, stress, anxiety and old emotions) and shift into divinity (lighter, calmer, freer states). The effects of Breathwork are felt immediately and ripple into all areas of your life.


